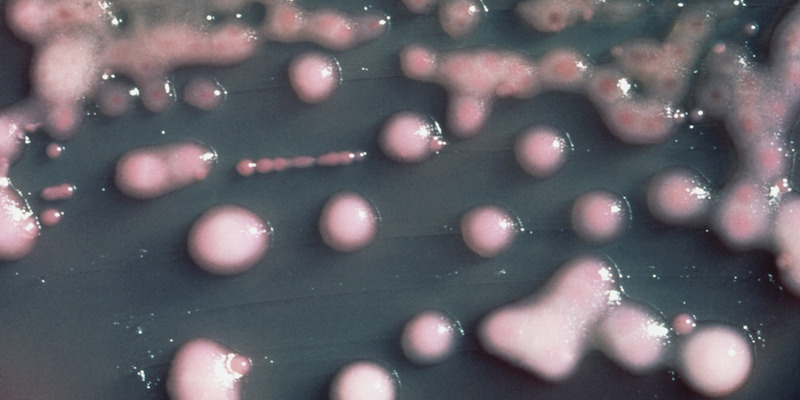

Un batterio che dovreste conoscere
Lo Klebsiella pneumoniae è uno di quei patogeni che si sono adattati agli antibiotici e ora sono un pericolo per le persone ricoverate in ospedale, soprattutto in Italia
Gli ospedali possono essere pericolosi: ci andiamo per farci curare quando abbiamo qualcosa che non va, ma dato che lo fanno anche tante altre persone, sono posti in cui girano molti virus e batteri. Ovviamente vengono prese molte precauzioni per evitare che i pazienti prendano malattie che non avevano al momento del ricovero, ma quando i pazienti hanno le difese immunitarie basse – immunodepressi, si dice – può essere difficile. E diventa particolarmente complicato quando in giro c’è un batterio che si è adattato molto bene a tutti gli antibiotici prodotti per contrastarlo. In Europa negli ultimi anni, e in Italia in modo particolare, un batterio di questo genere si è fatto particolarmente notare: si chiama Klebsiella pneumoniae.
Normalmente il batterio Klebsiella pneumoniae vive negli intestini, senza causare problemi di salute ai proprietari degli intestini stessi. Se però si è immunodepressi, il batterio può infettare i polmoni (e causare una polmonite) oppure il sangue e il cervello (e portare a una meningite). Nell’ultimo decennio i casi di polmonite e meningite da Klebsiella pneumoniae sono molto aumentati perché alcuni ceppi del batterio hanno sviluppato una forte resistenza ai carbapenemi, un tipo di antibiotici che vengono usati, esclusivamente negli ospedali, per curare infezioni gravi che non si possono trattare con altri farmaci. In Europa si è passati da 341 morti causate nel 2007 dallo Klebsiella pneumoniae a 2.094 nel 2015.
Un gruppo internazionale di ricercatori, autore di uno studio pubblicato il 29 luglio su Nature Microbiology, ha analizzato il DNA dei diversi ceppi di Klebsiella pneumoniae resistenti agli antibiotici trovati in 244 diversi ospedali europei e israeliani. È uno degli studi più grandi realizzati in questo campo e ha confermato che sono soprattutto gli ospedali a favorire il diffondersi di questi ceppi. Molti si sono originati nei paesi dell’Europa meridionale, tra cui l’Italia in particolare, e in quelli dell’est: è successo probabilmente perché in questi paesi si è fatto un uso eccessivo di antibiotici per trattare le infezioni batteriche.
Gian Maria Rossolini, microbiologo dell’Università di Firenze e dell’Azienda Ospedaliero-Universitaria Careggi che ha partecipato allo studio, ha spiegato a Repubblica che «Klebsiella pneumoniae si sta trasformando in un problema di salute pubblica», perché quando una persona immunodepressa viene infettata da un ceppo resistente ai carbapenemi «le poche opzioni terapeutiche disponibili sono meno efficaci e più tossiche, e non a caso la mortalità sale oltre il 40-50 per cento».
Un rischio legato alle mutazioni resistenti agli antibiotici di Klebsiella pneumoniae è che, attraverso un processo chiamato “coniugazione batterica“, i batteri possono scambiare porzioni del proprio DNA con altri batteri, anche di altre specie: dunque i ceppi di Klebsiella pneumoniae resistenti ai carbapenemi possono trasferire questa capacità anche ad altre specie di batteri. Per evitarlo, consiglia lo studio, è importante che gli ospedali monitorino i casi di infezione da Klebsiella e analizzino il DNA dei batteri raccolti per tenere sotto controllo il diffondersi (o l’originarsi) dei ceppi resistenti. Allo stesso scopo è bene che a livello nazionale gli ospedali si tengano informati tra loro sulla diffusione delle epidemie locali. Alla fine del 2017 in Italia governo e regioni avevano approvato il Piano nazionale di contrasto dell’antimicrobico-resistenza, che già dovrebbe essere un buon punto di partenza, anche se è ancora presto per verificarne i risultati definitivi. Il piano non riguarda solo le resistenze agli antibiotici ma anche agli antifungini, agli antivirali e agli antiparassitari e, ha detto Rossolini, ha già permesso di interrompere l’aumento del numero di nuove resistenze, che negli ultimi dieci anni era sempre cresciuto.



